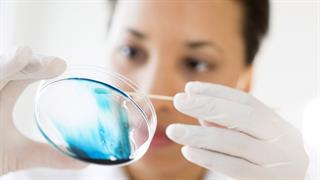
Ερευνητές ανέπτυξαν τεχνητούς, λειτουργικούς όρχεις

Παρασκευή, 17 Μαΐου 2024, 14:06
ΕΜΑ: Αποσύρεται από την Ευρώπη φάρμακο για διαταραχές τοκετούΤα οφέλη του δεν υπερτερούν των κινδύνων του, επισημαίνει η επιτροπή ασφάλειας του Ευρωπαϊκού Οργανισμού Φαρμάκων.
Πέμπτη, 16 Μαΐου 2024, 16:14
Διπλάσιος κίνδυνος καρδιακής νόσου σε γυναίκες που έκαναν θεραπεία υπογονιμότητας [έρευνα]Ασθενείς που υποβλήθηκαν σε τέτοια αγωγή ήταν κατά 2,16 φορές πιο πιθανό να χρειαστούν νοσηλεία για επικίνδυνα υψηλή πίεση.
Παρασκευή, 26 Απριλίου 2024, 12:42
Ανδρική υπογονιμότητα: Σχετίζεται με τη χρήση κινητών τηλεφώνων;Από την είσοδο των κινητών τηλεφώνων στη ζωή του σύγχρονου άνδρα, οι έρευνες έχουν στραφεί και στην πιθανότητα η ηλεκτρομαγνητική ακτινοβολία να συμβάλλει στην έκπτωση της ποιότητας του σπέρματος ανδρών κάθε ηλικίας.
Δευτέρα, 22 Απριλίου 2024, 12:53
Εξωσωματική γονιμοποίηση: Έχει καρδιολογικές επιπτώσεις;Τι αναφέρουν μελέτες για τον κίνδυνο καρδιαγγειακής νόσου μεταξύ των γυναικών που είχαν υποβληθεί σε εξωσωματική γονιμοποίηση και εκείνων που είχαν συλλάβει φυσιολογικά.
Τετάρτη, 21 Φεβρουαρίου 2024, 12:45
Ερευνητές ανέπτυξαν τεχνητούς, λειτουργικούς όρχειςΗ ανάπτυξη τεχνητών όρχεων προσφέρει στους επιστήμονες μοναδική ευκαιρία για την κατανόηση και την πιθανή αντιμετώπιση αιτιών υπογονιμότητας.
Πέμπτη, 01 Φεβρουαρίου 2024, 12:58
Υπογονιμότητα ανδρών: Προσοχή στην COVID-19Σε μελέτη διαπιστώθηκε ότι υπήρχε μείωση στον όγκο και στη συγκέντρωση του σπέρματος, στον αριθμό των σπερματοζωαρίων, στη συνολική κινητικότητά τους, καθώς και στον αριθμό των ζωντανών σπερματοζωαρίων.
Τρίτη, 19 Δεκεμβρίου 2023, 14:58
74 νόσοι σε νεαρή ηλικία συνδέονται με την ατεκνία εκατομμυρίων ανθρώπων [μελέτη]Η έρευνα είναι η πρώτη που εξετάζει συστηματικά πώς πολλές νόσοι σε νεαρή ηλικία συνδέονται με την ατεκνία σε άντρες και γυναίκες.
Παρασκευή, 24 Νοεμβρίου 2023, 16:41
Σχέση μεταξύ υπογονιμότητας γονέων και κινδύνου για αυτισμό στα παιδιά τους [μελέτη]Η έρευνα υποδεικνύει ότι ο κίνδυνος αυξάνεται σε παιδιά γονέων που προηγουμένως είχαν διαγνωστεί με υπογονιμότητα, άσχετα από το αν είχαν υποβληθεί σε θεραπεία για αυτήν.
Τετάρτη, 25 Οκτωβρίου 2023, 19:20
Η κετογονική διατροφή ενισχύει την επιτυχία της εξωσωματικής γονιμοποίησης σε γυναίκες με σύνδρομο πολυκυστικών ωοθηκών [μελέτη]Η έρευνα περιέλαβε μικρό δείγμα 84 ασθενών με το σύνδρομο, υπέρβαρων ή παχύσαρκων.
Πέμπτη, 28 Σεπτεμβρίου 2023, 13:31
Εγκαίνια Πολιτιστικού Κέντρου Δια Βίου Μάθησης ''Επαμεινώνδας Κελλάρης''Η δημιουργία του Πολιτιστικού Κέντρου έγινε με την υποστήριξη και επιμέλεια του κ. Βασίλη Κελλάρη, Γυναικολόγου Αναπαραγωγής και συνιδρυτή του Σωματείου Be-Live, στη μνήμη του πατέρα του Δημητρίου Κελλάρη.

![Διπλάσιος κίνδυνος καρδιακής νόσου σε γυναίκες που έκαναν θεραπεία υπογονιμότητας [έρευνα]](/media/articles/photos/thumb/124948-iolliskin.jpg)

![74 νόσοι σε νεαρή ηλικία συνδέονται με την ατεκνία εκατομμυρίων ανθρώπων [μελέτη]](/media/articles/photos/thumb/121499-childless1280.jpg)
![Σχέση μεταξύ υπογονιμότητας γονέων και κινδύνου για αυτισμό στα παιδιά τους [μελέτη]](/media/articles/photos/thumb/120855-119786autismboy1280.jpg)
![Η κετογονική διατροφή ενισχύει την επιτυχία της εξωσωματικής γονιμοποίησης σε γυναίκες με σύνδρομο πολυκυστικών ωοθηκών [μελέτη]](/media/articles/photos/thumb/120088-113391keto.jpg)

 Χρόνια νεφρική νόσος: Τι πρέπει να γνωρίζουμε
Χρόνια νεφρική νόσος: Τι πρέπει να γνωρίζουμε Πώς θα προλάβουμε τον διαβήτη
Πώς θα προλάβουμε τον διαβήτη Αλκοόλ και αντικαταθλιπτικά: Γιατί δεν πρέπει να τα συνδυάζουμε
Αλκοόλ και αντικαταθλιπτικά: Γιατί δεν πρέπει να τα συνδυάζουμε Μικροβιακή αντοχή: Μία πανδημία σε αργή κίνηση που μπορούμε να αποτρέψουμε
Μικροβιακή αντοχή: Μία πανδημία σε αργή κίνηση που μπορούμε να αποτρέψουμε